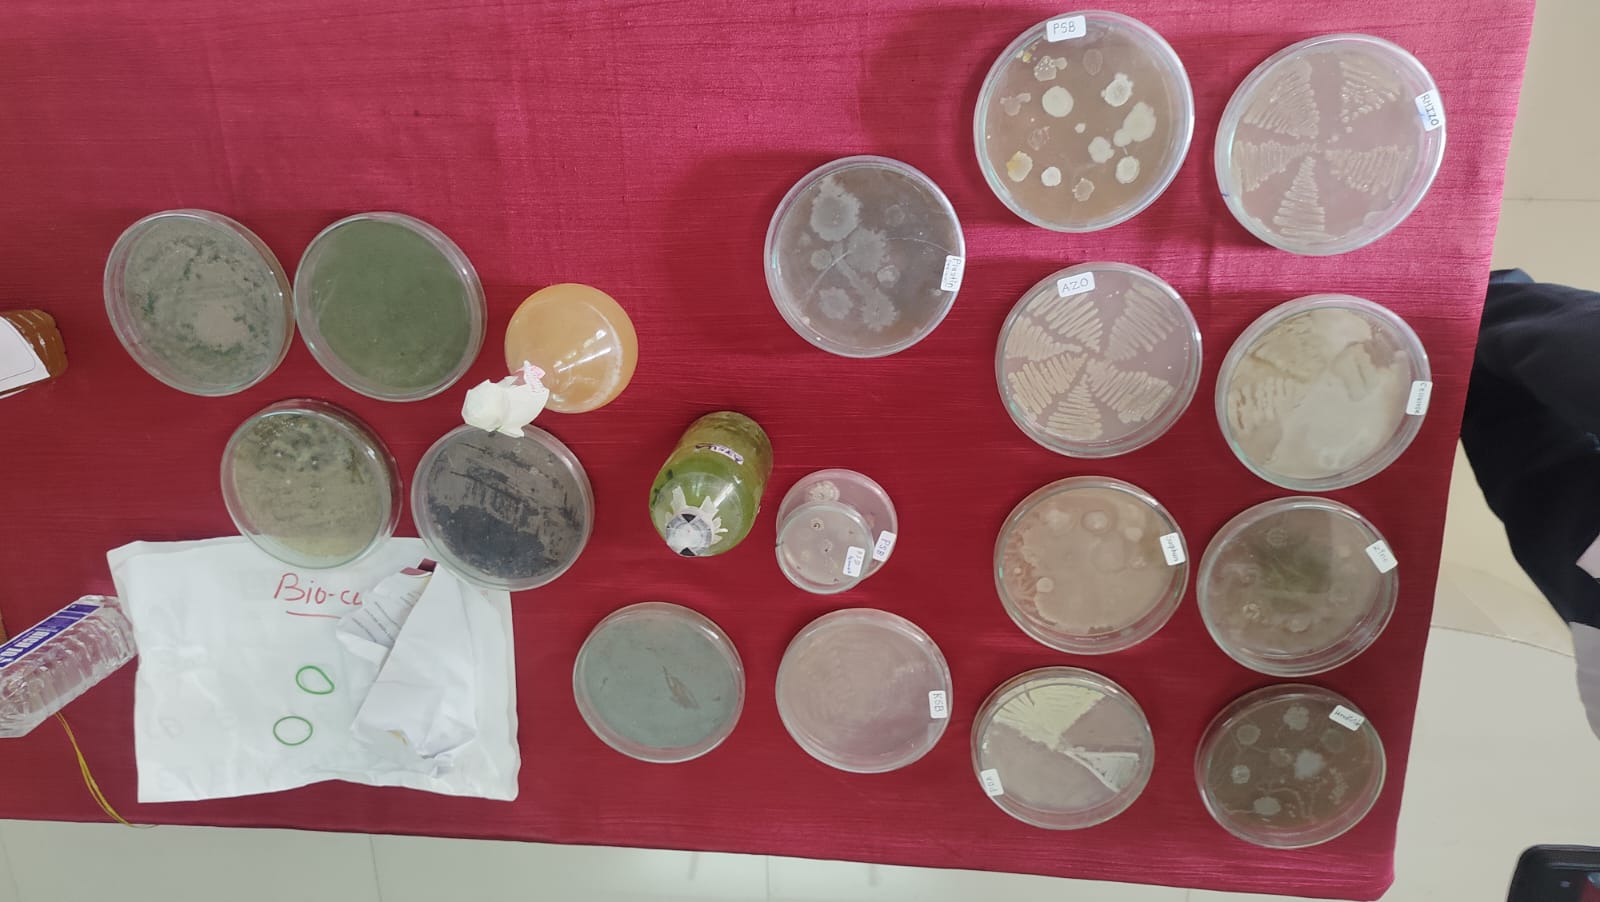
grow green grow smart

SHRI SHIVAJI SCIENCE COLLEGE, AMRAVATI
DBT STAR COLLEGE PROJECT ACTIVITY
ACTIVITY REPORT

Two days Hands on Workshop Biofertilizer Production and Distribution toFarmers
Activity Dates: 23–24 February 2026
Type of Activity: Students Workshop
Organizing Department: Department of Microbiology
Program Coordinators: Prof. Suwarna S. Mankar
Head of the Department: Dr. R. C. Maggirwar
External Collaborator (if any): No
Objectives:
- • To provide students with practical knowledge about the production of biofertilizers.
- • To create awareness about the importance of biofertilizers in sustainable agriculture.
- • To train students in basic microbiological techniques used in biofertilizer production.
- • To introduce students to beneficial soil microorganisms and their role in improving soil fertility
- • To encourage students to adopt eco-friendly agricultural practices and reduce dependency on chemical fertilizers.
No of Beneficieries: 50
Classes Involved: B.Sc students
Venue of the Activity: Department of Microbiology, Shri Shivaji Science College, Amravati
Activity Report:
Report on Two days Hands on Workshop Biofertilizer Production and Distribution toFarmers
Date: 23–24 February 2026
A two-day Hands-on Training Workshop on Biofertilizer Production was organized on 23rd and 24th February 2026 for the students of Biotechnology and Microbiology. The workshop aimed to provide students with practical exposure to biofertilizer production techniques and to increase awareness about sustainable agricultural practices. The training program was conducted in the microbiology laboratory with active participation from students and faculty members.
The workshop was conducted under the expert guidance of Dr. Sanjay Gulhane, who was invited as the guest and resource person for the program. Dr. Gulhane shared his knowledge and experience in the field of microbial biotechnology and biofertilizer production. The program included both theoretical lectures and practical demonstrations to help students understand the complete process of biofertilizer production.
Objectives of the Workshop:
The main objectives of organizing the workshop were:
• To provide students with practical knowledge about the production of biofertilizers.
• To create awareness about the importance of biofertilizers in sustainable agriculture.
• To train students in basic microbiological techniques used in biofertilizer production.
• To introduce students to beneficial soil microorganisms and their role in improving soil fertility.
• To encourage students to adopt eco-friendly agricultural practices and reduce dependency on chemical fertilizers.
Introduction to Biofertilizers
During the lecture session, Dr. Gulhane explained the concept and importance of biofertilizers in modern agriculture. Biofertilizers are preparations containing beneficial microorganisms that enhance soil fertility by increasing nutrient availability to plants.
He discussed important microorganisms used in biofertilizer production such as Rhizobium, Azotobacter, and Azospirillum which are capable of fixing atmospheric nitrogen. He also explained phosphate-solubilizing microorganisms such as Bacillus and Pseudomonas, which help plants absorb phosphorus more efficiently. The lecture emphasized that the use of biofertilizers helps in improving soil fertility, increasing crop productivity, and reducing environmental pollution caused by excessive use of chemical fertilizers.
Benefits of Biofertilizers Improves Soil Fertility Biofertilizers contain beneficial microorganisms that increase the availability of nutrients in the soil, improving overall soil fertility. Nitrogen Fixation Certain microorganisms such as Rhizobium, Azotobacter, and Azospirillum convert atmospheric nitrogen into forms that plants can easily absorb. Phosphate solubilisation. Some bacteria like Bacillus and Pseudomonas help dissolve insoluble phosphate in soil, making it available for plant uptake. Eco-Friendly and Sustainable Biofertilizers are environmentally friendly and help reduce pollution caused by excessive use of chemical fertilizers. Improves Crop Yield They enhance plant growth and productivity by improving nutrient uptake and stimulating plant growth. Maintains Soil Health Continuous use of biofertilizers improves soil microbial activity and maintains the natural balance of soil microorganisms. Cost Effective Biofertilizers are cheaper compared to chemical fertilizers and reduce the overall cost of farming. Enhances Plant Growth. They produce growth-promoting substances such as vitamins and hormones that stimulate plant development.
Practical Training Session
The most important part of the workshop was the practical training session where students gained hands-on experience in biofertilizer production. Under the guidance of Dr. Gulhane and faculty members, students performed various laboratory procedures related to microbial culture and biofertilizer preparation.
The practical activities included:
• Preparation of culture media for the growth of beneficial microorganisms.
• Sterilization of laboratory equipment and media using proper aseptic techniques.
• Inoculation and cultivation of microbial cultures.
• Mass multiplication of microorganisms required for biofertilizer production.
• Preparation of carrier materials such as peat soil and lignite.
• Mixing microbial cultures with carrier materials to prepare biofertilizer formulations.
• Packaging and storage of biofertilizer products.
Through these practical exercises, students learned the step-by-step procedure involved in biofertilizer production and gained confidence in handling microbiological techniques.
Demonstration of Application Methods
On the second day of the workshop, a demonstration was given on the different methods of applying biofertilizers in agricultural practices. Dr. Gulhane explained various application techniques such as seed treatment, seedling root dipping, and soil application.
Students learned that proper application of biofertilizers enhances plant growth by improving nutrient uptake and promoting beneficial microbial interactions in the soil. The importance of proper storage conditions and quality control of biofertilizer products was also discussed.
Interactive Session
An interactive discussion session was conducted at the end of the training program. Students actively participated and asked questions related to microbial culture techniques, biofertilizer production methods, and career opportunities in agricultural biotechnology. Dr. Gulhane encouraged students to explore research and entrepreneurial opportunities in biofertilizer production. He highlighted the increasing demand for biofertilizers due to the global focus on sustainable agriculture and environmental conservation.
Outcome of the Workshop
The workshop was highly beneficial for the students as it provided both theoretical knowledge and practical exposure. The main outcomes of the workshop were:
• Students gained hands-on experience in microbial culture techniques and biofertilizer production.
• Participants developed a better understanding of the role of beneficial microorganisms in agriculture.
• Students became aware of eco-friendly alternatives to chemical fertilizers.
• The workshop enhanced students’ practical laboratory skills and scientific knowledge.
• It motivated students to explore future research and career opportunities in biotechnology and sustainable agriculture.
Conclusion
The Hands-on Training Workshop on Biofertilizer Production conducted on 23rd and 24th February 2026 was a successful and informative program. The expert guidance of Dr. Sanjay Gulhane helped students understand the scientific principles and practical applications of biofertilizers. The workshop effectively achieved its objectives by providing practical training and promoting awareness about sustainable agricultural practices. Students benefited greatly from the opportunity to learn directly from an expert and to perform laboratory procedures related to biofertilizer production. Such training programs play an important role in developing scientific skills among students and encouraging the adoption of
Environmental friendly agricultural technologies. The organizers expressed their sincere gratitude to Dr. Gulhane for his valuable contribution and for making the workshop an enriching learning experience for all participants.
Benefits of the Workshop
• The Hands-on Training Workshop on Biofertilizer Production provided several academic and practical benefits to the B.Sc. Third Year students. The training helped students understand the practical aspects of microbial biotechnology and its applications in sustainable agriculture.
• Students gained hands-on experience in laboratory techniques such as media preparation, sterilization, inoculation, and microbial culture handling.
• The workshop improved students’ understanding of biofertilizer production processes and the role of beneficial microorganisms in agriculture.
• Participants learned about important biofertilizer microorganisms such as Rhizobium, Azotobacter, and Azospirillum that enhance soil fertility.
• Students developed awareness about sustainable and eco-friendly farming practices and the need to reduce the use of chemical fertilizers.
• The training enhanced students’ practical skills, scientific thinking, and confidence in performing microbiological experiments.
• It also provided exposure to career opportunities and research areas in agricultural biotechnology and biofertilizer production.
• Overall, the workshop helped students connect theoretical knowledge with practical applications and encouraged them to contribute to environmentally sustainable agricultural practices.
Outcomes:
- Students gained hands-on experience in laboratory techniques such as media preparation, sterilization, inoculation, and microbial culture handling.
- The workshop improved students’ understanding of biofertilizer production processes and the role of beneficial microorganisms in agriculture.
- Participants learned about important biofertilizer microorganisms such as Rhizobium, Azotobacter, and Azospirillum that enhance soil fertility.
- Students developed awareness about sustainable and eco-friendly farming practices and the need to reduce the use of chemical fertilizers.
- The training enhanced students’ practical skills, scientific thinking, and confidence in performing microbiological experiments.
Photos:
 Biofertilizes production workshop and distribution to farmers | grow green grow smart |
 Learn Apply Grow |  science in action |
 future ready agriculture skills |  Practical biofertilizer skills |
Attendance Sheet:
 |
 |